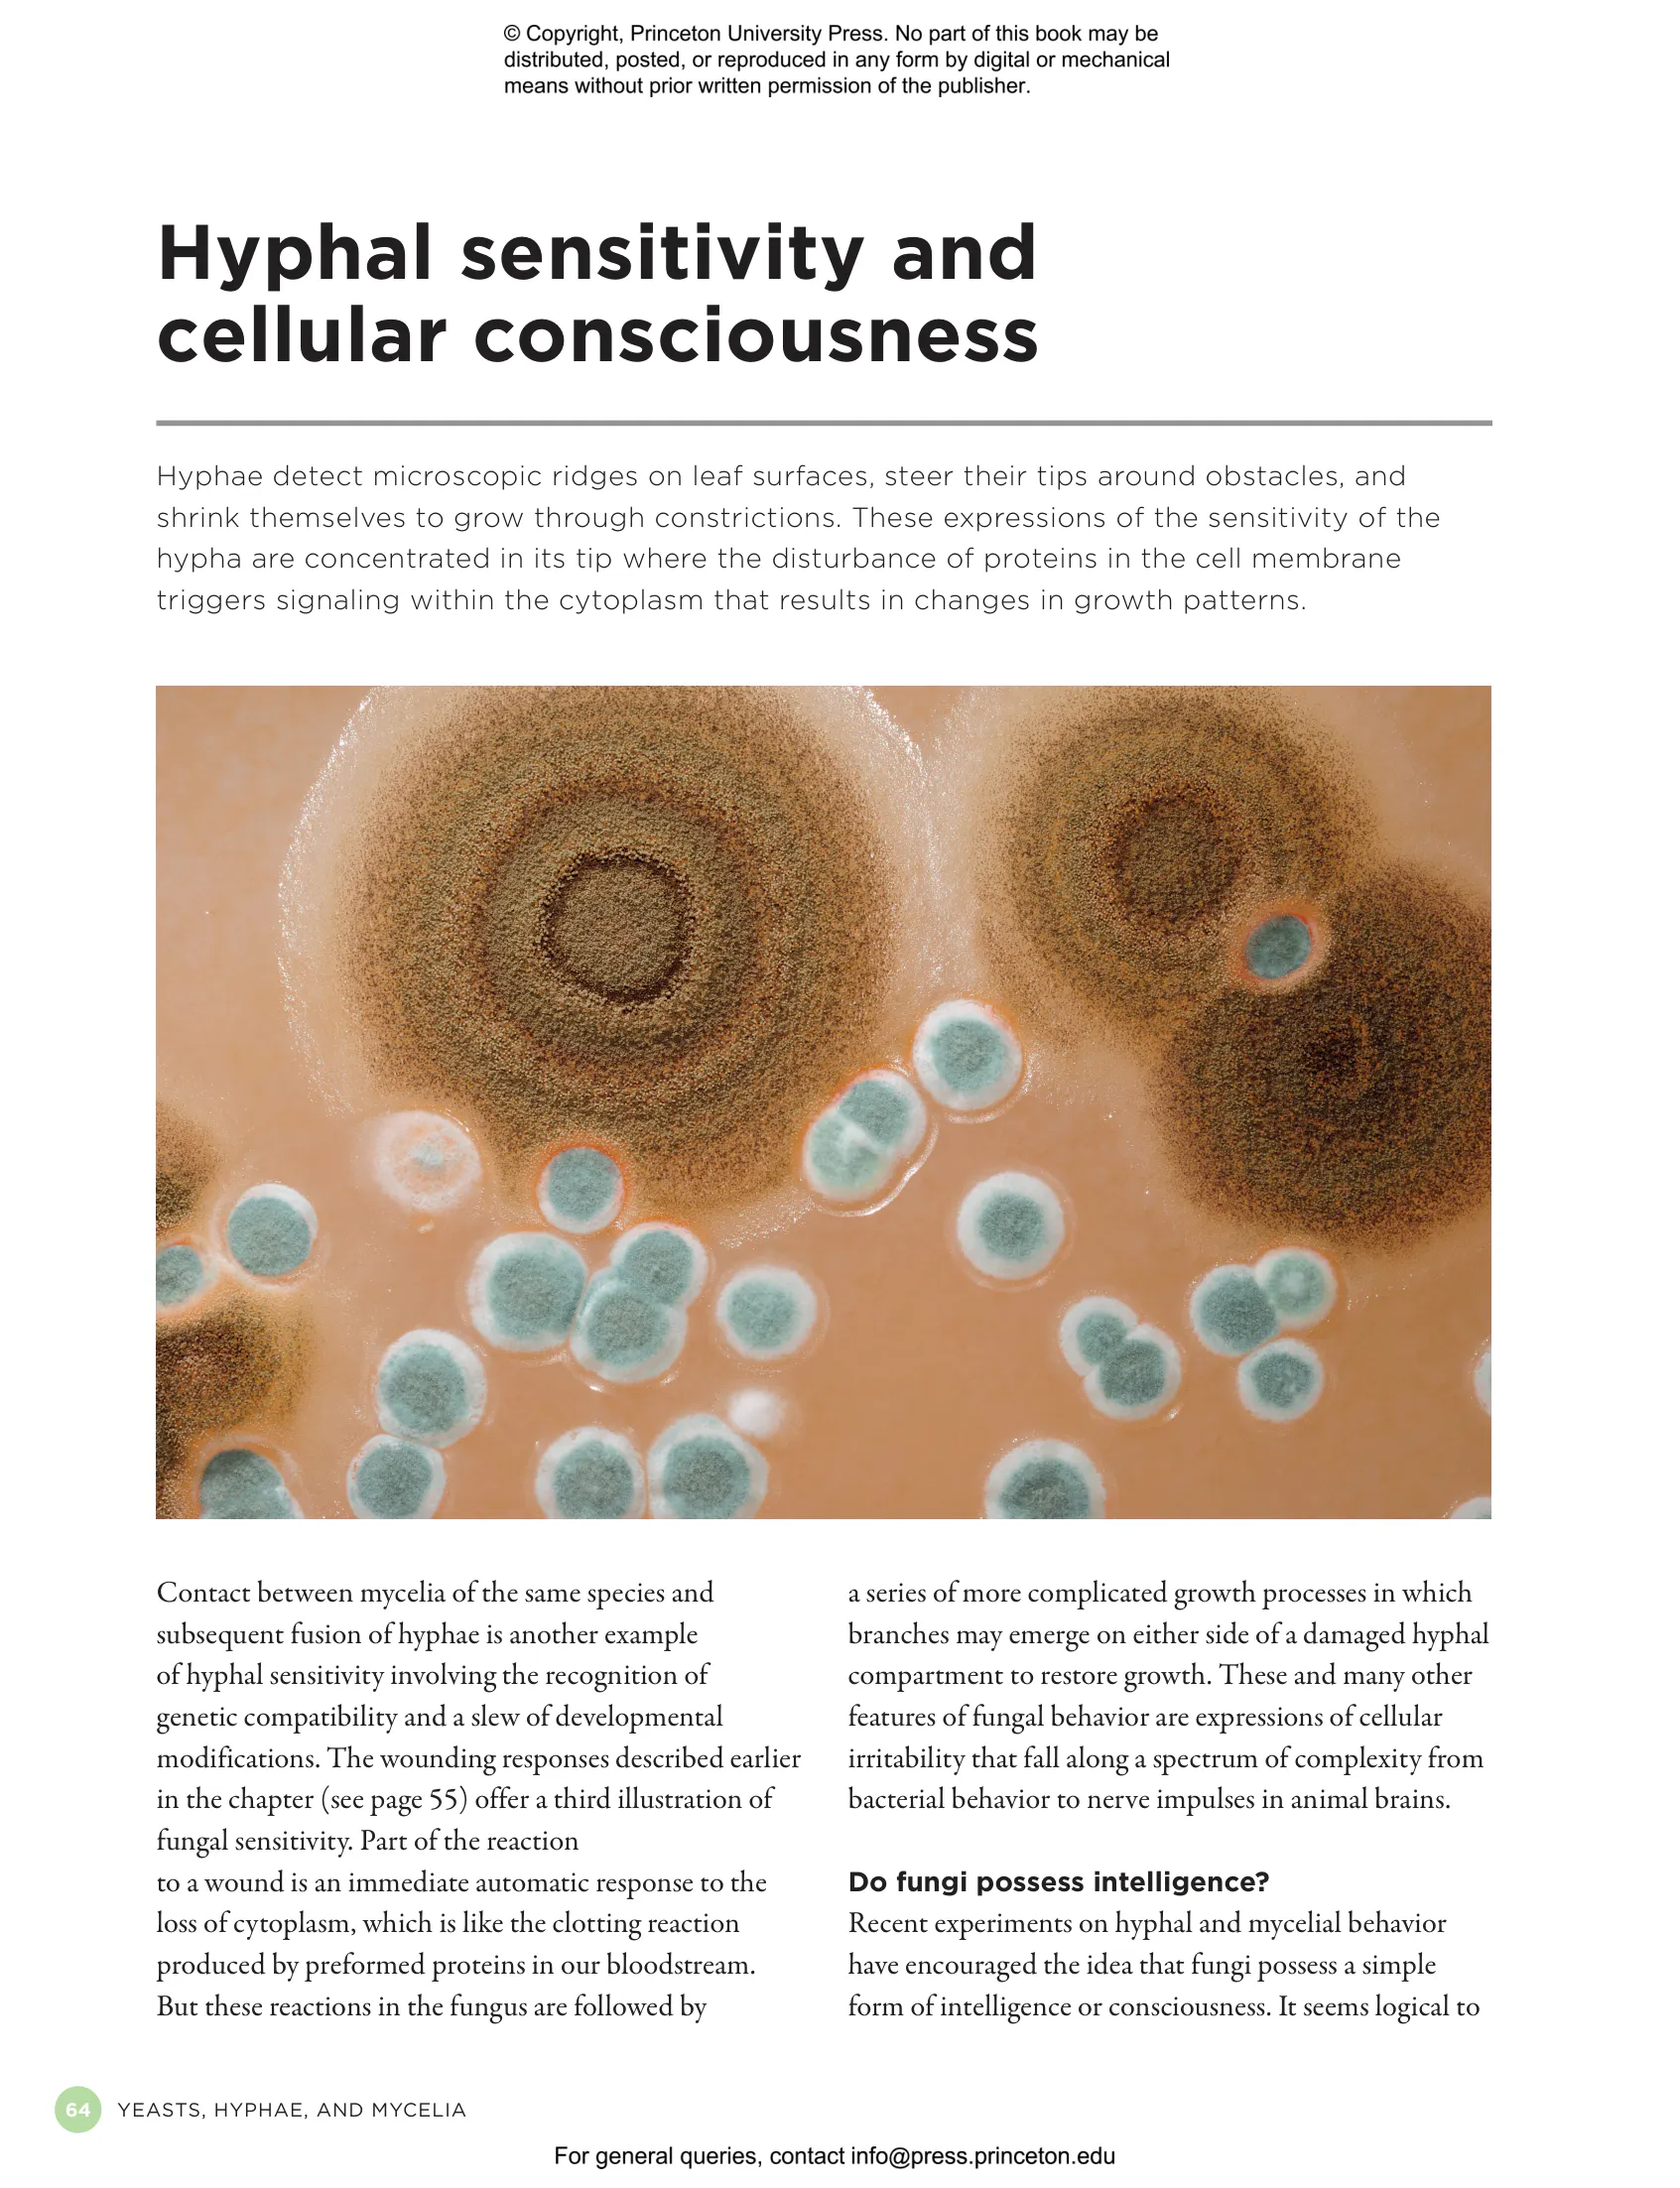

The Complete Fungi: Evolution, Diversity and Ecology


Hardcover
ebook (EPUB via app)
ebook (PDF via app)
- Sale Price:
- $27.97/拢24.50
- Price:
-
$39.95/拢35.00 - ISBN:
- Published:
- May 5, 2026
- Copyright:
- 2026
- More than 400 color illus.
30% off with code PUP30
-
Audio and ebooks (EPUB and PDF) purchased from this site must be accessed on the
快色直播 app. After purchasing, you will receive an email with
instructions to access your purchase.
About audio and ebooks - Request Exam Copy
Occupying an entire kingdom of their own, fungi comprise over 155,000 species that include yeasts, rusts, and molds as well as the more familiar mushrooms and toadstools that we see in the wild and on our plates. Found widely across the globe, they represent a diverse group of organisms, some living freely in soil and water, and others forming parasitic or symbiotic relationships with plants, algae, and animals. This book presents a broad and accessible overview of fungal diversity, evolution, and ecology. It describes the various forms of fungi and covers topics ranging from fungal origins and reproduction to the historical and cultural significance of fungi for humankind. Blending stunning illustrations with a lively and engaging text, The Complete Fungi is a must for fungi enthusiasts and armchair naturalists alike.
- Features a wealth of photos and infographics
- Discusses the relationship of fungi to plants, animals, and protists in the tree of life
- Describes the features that distinguish fungi from funguslike organisms such as slime molds and oomycetes
- Highlights the major life-forms of fungi such as yeasts and filamentous fungi
- Looks at the elaborate life cycles of fungi and how they reproduce sexually and asexually
- Sheds light on the multicellularity in fungi and the diverse ways fruiting bodies adapt to the challenges of spore dispersal
- Explores interactions of fungi with plants and animals